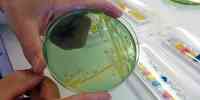
Bakterier

Nyheter
Resultat: (2470) Viser 721 - 750

Søkelys på økosystemet i Skagerrak
16.12.2022

Ser inn i Nordens klima-framtid
16.12.2022

Linn Cecilie Moholt blir ny digital direktør
13.12.2022

kronikk
Hva betyr klimaendringene for norsk sjømat?
12.12.2022

kronikk
Solid ballast for videre kystnær kartlegging
08.12.2022

Kartlegger korallrevet ved Tisler
07.12.2022
kronikk
Avføringen avslører deg
06.12.2022

Lite bifangst i krillfisket i Sørishavet
05.12.2022

Anbefaler økning i snøkrabbekvoten
01.12.2022

Hummar i reservat vaks raskare
28.11.2022

Store mengder trålspor nord for Svalbard
24.11.2022

Laks blir ikke immun mot lakselus
21.11.2022
Veksten påvirker makrellens vandringer
21.11.2022

Finner blåskjell i alle regioner
15.11.2022

Oppdatert kvoteråd for nordsjøtorsk
08.11.2022